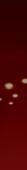

Noorthside
THE QUALITY MAGAZINE
AZINE FOR LEEDS, HARROGAATTE & SURROUNDIN
HARR
G AREAS





























Wa W
Experience the
Warmth and WONDER k.


udley Scarcroft Park located just eight miles from Leeds and set within 110 acres of beautiful land and offffers luxury retirement properties in and around the restored Grade II listed building.
e festive season at Audley Scarcroft Park




will take place, featuring a collect
festive music and refreshments as comes alive with Christmas cheer
AtthecentreofthevillageistheAudley
At the centre of the village is the Audley
w f c s A
simplytosoakupthejoyfulatmos
ion of local the village . It’s the sphere
and exercise classes, spa treatment rooms and a hair salon. There is a bar bistro for casual dining and the a la carte restaurant, s at Scarcroft Park, of Thackaray’ fffersformal dining. Additionally, there is a private dining room for any special occasions, all of which is open to the public to enjoy alongside the Audley owners. At Scarcroft Park owners can also relax in the library and owners’ lounge within the centrepiece building.
This December, visitors can embrace the warmth and wonder of the festive season at Scarcroft Park.
On Sunday 3rd December, from 11.00am to 3.00pm, the much-loved Christmas Fair
simply to soak up the joyful atmosphere. Throughout December, guests can enjoy a festive Afternoon Tea or dine from the special festive menu, available to both owners and the public. As the year draws to a close, celebrations will continue with Y a New Yeear ’s Eve event - an evening of
company. And to welcome 2026 in style, a Y New Yeear ’s Day brunch is being served in the elegant restaurant, offffering good food and great conversation to start the year.
Paul Donkin, General Manager at Audley Scarcroft Park, shares: “There’s something truly special about Audley Scarcroft Park at this time of year. The village comes alive with friendship, laughter and shared experiences. It’s a wonderful community
to be part of, a plac involved, make ne at home.”
ce where people can get ew friends, and really feel
The future is alw one tailored to you live the life you lo valuedindependen
ways brighter when it’s u. At Audley you can ve, keep your highly nceandownyourown
valued independence, and own your own property, because when you’ve worked hard to become the person you are today, Audley believes you shouldn’t have to change your lifestyle when you retire. They look after the maintenance and security of your property and the grounds, leaving you free to spend your time however you wish. Care and support services are also on hand should you ever need it.
Exclusively for over 60 year olds, owning a home at Scarcroft Park gives you a truly independent lifestyle in a beautiful and secure environment. If you or someone you know would like to explore this village with tour a private r, , please email scarcroftsales@ k or call 0113 397 1404.
audleyvillages.co.uk
NEMERITE Y R
aP t ftof rehW tee y m ruxu d l n y a trebi e l offersdininginexqui o the public, T Open t ed Gortes ound the r ar ers luxur open and off udle eeds, A o Lclose t es o Set within 110 acr oundings, ry’anttauress a ed building. tade II Glis r operties in and ry pr w ark is no oft Pcry Scar of beautiful land, and
LL





it siv/ku. co .sega ll ivyeldua erotmudoniF acilities. e f health and leisur vides luxurious o y Club pr udle t the A whils e surr xquisit ers dining in e off
31SL s dee,LtforcracS , enadLoowlleH 40471933110
DECEMBER ‘25
ARTS/CULTURE
14 The Diary
Our monthly round-up of what’s happening in your area 20 What’s Going On? of 2025
CHRISTMAS
27 Party piece(s)
Small plates are the way forward this festive season. Here are some great occasion dishes to try at home.
30 Christmas Gift Guide
Get inspiration from the independents this festive season
32 Bumper Xmas Quiz
Test your mettle in our festive brainteaser
36 Fashion
Whether you’re dressing to impress or hibernating at home, this seasonal picks have you covered
44 Beauty
Make sure you’re on top of your beauty gift game with this collection of festive crackers
With the growing trend for nonalcoholic varieties, we put a series of wines to the test
And the winners are
Our sister magazines held their annual restaurant and bar awards with special prizes for ‘out of town’ establishments


Welcome to our December edition.
It’s beginning to look a lot like Christmas...
Keeping things festive, we have your food and drink plans covered with a focus on Christmas snacks as well as tasting the latest nonalcoholic wines. Perfect for the designated driver.
We also have a gift guide and quiz and speak to Leeds Playhouse about their forthcoming pantomime.
Fashion and beauty have a festive slant and if you’re decking your halls - and everything else - we have some colourful inspiration.
We also have a review of our sister magazines’ 2025 Restaurant & Bar Awards, of which we had some special awards for restaurants in this region.
Next month is our special Northern Lifestyle guide.
Merry Christmas.
Richard Abbey Executive Editor


call
email: Amanda Roy 07843 633184 amanda.roy@rmcmedia.co.uk Tracy Stacey 07446 244589 tracy.stacey@rmcmedia.co.uk



































































































































































































































































































































Champagne + FROMAGE
Christmas is a time to sparkle and this Harrogate venue is all set to put the
hampagne + Fromage is the perfect pairing bringing together delicious deli-style meats and cheeses with carefully selected
Whatever the occasion the corks are always popping at this cosy bistro-style
But this Christmas you can expect some extra sparkle with festive additions to the menu and some delicious Champagnes to
Mont d’Or (also known as Vacherin or Vacherin Mont d’Or) is a specialist French cheese from the Jura mountains,
soft, creamy seasonal cow’s milk cheese is production uses the rich and sweet milk itself is put in round wooden boxes, in the case of Mont d’Or cheese these are made of cut spruce bark and known as sangles, and this helps give it its delicate resin aroma
can be spooned straight from the box or
At Champagne + Fromage it will be served warm and other seasonal dishes including backed camembert with sage
in blankets will be on the menu alongside a host of deli delights, perfect for sharing
of Champagne + Fromage is the only one in Yorkshire and the most northerly in the
to the town this Christmas and New Year as the perfect place for a seasonal get-together whether you’re swapping presents with an old friend, enjoying a festive date night or meeting up with colleagues to toast the holidays!
More than a champagne and wine bar, but not a full-blown restaurant, this bistro-style venue is perfect for a host of occasions but also makes the perfect place to stop for a break from Christmas


shopping or just because you fancy a little
A Champagne to suit every palate
Champagnes are sourced from the region’s smaller vineyards – giving customers superb choices of grape varieties and the chance to taste a Champagne they may not
Expert staff can guide you through the options, whether you like a very dry, or fruity wine, and lots of bubbles or not so many? And of course, the drinks served here are the perfect accompaniment to the
cheeses, sausage, cured and smoked meats–are delivered via Une Normande a Londres, a supplier which selects the best authentic French ingredients from Aquitaine to
Christmas is for sharing the love, and it’s all about sharing here – whether that’s the Gastroboards, which includes a mix of
And with just 38 covers and tables that

accommodate couples, fours or small groups, this is about intimate dining, in a convivial atmosphere with relaxing background music which won’t intrude on
Say cheers!
come in glasses specially designed not only to help the Champagne keep its sparkle for longer, but to allow the full aromas of the
the glass, as well as bottles, and a smaller, but equally carefully selected, list of red,
Make a date: Champagne + Fromage is open every day except Monday from noon to 10pm (last food orders at 9pm). You can book online or phone to make your request, on 01423 226561. And you can also buy Champagne, wines, cheeses and meats directly for enjoying at home. Just check the website here for more details. And don’t forget to follow them on Facebook and and tastings, or sign up for their newsletter.














BOOKING NOW








rtsAr lture






















The Diary
THEATRE MUSIC COMEDY EVENTS EXHIBITIONS FILM FURTHER AFIELD...

Welcome, to the PANTOMIME
Our region is well covered for famliy entertainment this festive season. Here’s our pick of the pantos.
Kenny Davies in last year’s production of Jack & The Beanstalk at Leeds’ City Varieties Music Hall Image courtesy Ant Robling
amilies throughout the region
festive season for that great British tradition – pantomime.
anthems and pop hits. From singalong

reliving their favourite hits.
Sleeping Beauty
21 November-4 January
Carriageworks Theatre, Leeds www.carriageworkstheatre.co.uk
on a spinning wheel and sleep for 100
Last year’s Cast production of Jack & The Beanstalk
Jack & The Beanstalk
26 November-18 January Harrogate Theatre www.harrogatetheatre.co.uk

Cinderella
28 November-4 January / Cast Doncaster castindoncaster.com
Cinderella is left behind. But with a wave
Aladdin: The Rock ‘N’ Roll Panto
28 November-11 January City Varieties Music Hall leedsheritagetheatres.com

Snow White
29 November-4 January
Rotherham Civic Theatre www.rotherhamtheatres.co.uk
Sleeping Beauty
2 December-4 January York Theatre Royal www.yorktheatreroyal.co.uk show.
Rapunzel
6-31 December / Doncaster Little Theatre doncasterlittletheatre.co.uk
this is a tale to be untangled. Written by

Theatre
Miss Saigon
2-13 December
Leeds Grand Theatre leedsheritagetheatres.com
A Christmas Carol
20 November-17 January
Leeds Playhouse www.leedsplayhouse.org.uk
meaning of Christmas.
at the Playhouse for Christmas 2025.
for all
6 December-4 January
Leeds Playhouse www.leedsplayhouse.org.uk the team behind Zog and Zog and the
Christmas with Anton Du Beke
1 December
Royal Hall, Harrogate www.harrogateconventioncentre.co.uk
your Christmas with his beautiful show. laughter.
Classical
An Evening with Nicola Benedetti
4 December
Royal Hall, Harrogate www.harrogateconventioncentre.co.uk
Music
Swing Into Christmas
5
Harrogate Theatre www.harrogatetheatre.co.uk
with strings is one of the largest swing
with her thoughts surrounding her
Comedy Christmas
Jimmy Carr: Laughs Funny
13 December
First Direct Bank Arena, Leeds
Wolf Alice
5 December
First Direct Bank Arena, Leeds

Experience
a Magical Leeds Christmas.
From spectacular shows and seasonal shopping to enchanting experiences and family adventures, where twinkling lights set the backdrop to unforgettable moments. Leeds is the merriest place to be this Christmas.

Seasonal Shopping
Leeds Christmas Markets
From 21 November to 21 December, City Square will dazzle with festive charm when up to 60 beautifully decorated chalets take over the space with offerings from local, national and international traders as well as two bars –the Ranch Bar and The Windmill Bar – serving up seasonal cheer.
Whether you’re on the hunt for unique artisan gifts or warming up with a sweet cup of mulled wine, Leeds Christmas Market at City Square is brimming with handcrafted delights and festive foodie favourites. At the heart of the city, on Millennium Square and Victoria Gardens, you’ll find festive market stalls alongside family-favourite Christmas rides, including the Carousel, the Big Wheel and Ice Cube ice-skating from 21 November to 31 December. At Bond Court, local favourite Little Bird Markets will be hosting a local makers market from Thursday to Sunday from 20 November to 21 December.
As one of the UK’s top shopping destinations, Leeds is the place to get your Christmas shopping wrapped up. You’ll find all your favourite high-street names and a dazzling array of luxury brands alongside unique independent shops and local artisan makers. And the best part? You’ll find all this and more within stunning Victorian arcades at Victoria Leeds, Thornton’s Arcade and Queens Arcade, as well as striking architectural landmarks Leeds Corn Exchange and Kirkgate Market, which are at their best when decorated with breathtaking Christmas trees and illuminated by cascading lights. In Leeds, it’s not just about the shopping, it’s a chance to spend time with family and friends, soaking up the atmosphere and enjoying the delights of the season.

Victoria Gate c Chris Heaney
City Square Christmas Markets
c Chris Heaney

Unforgettable Moments
Create magical memories with friends and family at one of Leeds’ beautiful historic homes and estates.
The picturesque gardens of Temple Newsam will be transformed with Northern Lights Leeds; taking visitors on a jaw-dropping journey through a spectrum of illuminations and unique musical compositions, culminating in a Christmas village serving up hot food and drinks from 21 November to 31 December.
On weekends from 6 to 20 December, step inside Temple Newsam for the Christmas Tree Trail featuring over 25 uniquely decorated Christmas trees reflecting different themes throughout the house.
Explore the festive wonder of Lotherton’s beautifully decorated hall and grounds at The Christmas Experience from 22 November to 4 January, with enchanted trails, crafts, toasted marshmallows, weekend magic shows at the Elf Village and of course the chance to meet Santa and Mrs Claus.
Christmas at Harewood is the perfect time to create festive memories that last a lifetime. The house and grounds will once again shimmer with Christmas splendour for this year’s theme: A Glittering Invitation. From the first notes of Regency music to the vibrant glow of Christmas trees, anticipation fills the air as guests arrive for the evening’s festivities. Follow the story of a glittering host as she welcomes guests for dinner before the evening unfurls into the Gallery where gowns and tailcoats swirl beneath twinkling Christmas lights. Wander through rooms alive with colour, pattern and festive decadence, as Harewood’s Grand Christmas Ball whirls into full swing. Open from 8 November to 4 January.
Enchanting Evenings
Take the chance to have a night out at the theatre, and with four fantastic state-of-the-art theatres in Leeds city centre, there are plenty of spectacular shows to choose from. Leeds Playhouse is bringing Charles Dickens ‘A Christmas Carol’ to life with a brand-new production from 20 November to 17 January. The ever-popular Rock n Roll Panto returns to City Varieties Music Hall with a re-telling of Aladdin from 28 November to 11 January. At Leeds Grand Theatre Northern Ballet present their award-winning version of The Nutcracker from 18 December to 4 January. And the family favourite traditional Carriageworks Theatre pantomime returns this season with a lively version of Sleeping Beauty from 21 November to 4 January. That’s not to mention the multitude of live music, comedy and performances to be found across the city this festive season, from candle-lit concerts of Christmas favourites in Leeds Minster, Leeds Cathedral and Leeds City Museum to a series of Christmas comedy specials at The Glee Club. You’re guaranteed to be entertained during your time in Leeds. And with some of the best restaurants, pubs and food markets in the UK and a wonderful selection of hotels to stay in, it’s the perfect place to create unforgettable Christmas memories. For Christmas events listings, map and the Ultimate Guide to Christmas in Leeds scan the QR code or search ‘Leeds Christmas’
Harewood House c Harewood House Trust & Anthony Hicks
vibes (and much more) CHRISTMAS
The last month of the year has rolled around, and to be honest, I’ve been deep in Christmas vibes for weeks already. Once the invites for gettogethers, launches, work dos and early Christmas parties start landing, celebrations are ON.
Every year it feels like the city slips into festive mode a little earlier, but honestly? I’m not complaining. December has always been my favourite kind of chaos. And along with all the parties, it’s been one of the busiest periods for launches that I can remember - the kind of month that reminds you why Leeds is one of the most exciting cities in the UK!
Let’s start with India Bistro, which
Allerton. This isn’t just another opening it’s a serious step up for Indian dining in North Leeds. The restaurant is absolutely stunning, blending modern design with warm touches, and the menu takes muchloved classics and elevates them in all the right ways. It’s one of those places where you walk in and immediately think, “Yes. This is going to be good.” And it really is.
Big news for city-centre brunchers House of Koko has opened its newest venue on Central Road, taking over the former Mrs Atha’s spot. After what felt like years of dodging endless
steak and eggs remains, in my opinion, the perfect way to start the day simple, satisfying and beautifully done. But if heading into town isn’t on your pre-10am agenda, the Chapel Allerton location has just launched a fresh
unreal. A must-try!
Meanwhile, long-standing Leeds favourite Blackhouse has announced a major upgrade, giving the much-

loved restaurant a refreshed identity as it heads into nearly two decades of service. It’s rare to see a classic evolve
pull it off, it’s this one.
Joining the December excitement is Madre, landing in Leeds and ready to spice up the bar scene. What I love about this brand is the story (that, and its banging margaritas!). The founders travelled across Mexico City, Guadalajara and Oaxaca, learning, tasting and soaking in everything that makes the country’s food and hospitality so special. Now, they’re bringing those experiences to Leeds with their third restaurant following in the footsteps of Manchester and
vibes and expect to see this place on everyone’s feed this party season.
For fans of great coffee and legendary brunch plates, Federal has Yorkshire café in Leeds.
Born in Manchester in 2014 and inspired by Kiwi and Aussie café culture, Federal has earned a global reputation for exceptional brunch, killer coffee and the kind of service that makes you want to become a regular before you’ve even paid the bill. Leeds brunch lovers are going to be obsessed.
Outside the world of food, December also means theatre season and one of my all-time favourite shows returned to Leeds Grand, The Book of Mormon. Outrageous, offensive in the most brilliantly written way, and guaranteed to have you crying with laughter. If you haven’t seen it, go next time they’re in town.
Leeds Heritage Theatres has a packed winter season lined up, perfect for escaping the cold. Highlights include the beautiful, ballet-meetsfairytale production of Edward Scissorhands, the always-magical Nutcracker and a dark, atmospheric reimagining of Frankenstein, ideal for anyone wanting something with a little more edge.
As we close out another amazing year for PGHL packed with exciting launches, brilliant brands and unforgettable events I’m already buzzing about what’s coming next. There’s plenty of big news on the horizon for the city next year, and we can’t wait to share it with you.
And with that, I’m signing off. Have a wonderful Christmas and I’ll catch up with you all in 2026.





Book of Mormon
House of Koko has taken over the former Mrs Atha’s Madre Leeds is now open
Federal canned iced Matcha, took social media by storm
India Bistro is now open in Chapel Allerton






















































































































































































































































Habitat 10ft Christmas tree
CHRISTMAS
Let’s be honest, we all overindulge over the festive season. It’s hard not to. There’s so much food, drinks, parties, gatherings… how can you say no?
But Christmas is not all about big heavy meals, sometimes those smaller bites, and smaller plates, can go a long way.
With this in mind, we have spoken to a trio of chefs and cooks seeking inspiration for smaller, buffet-style dishes that can be easily enjoyed at home.
and home cook and has been guest chef at various restaurants around the region.
Morocco, South Asia and some fusion
“The okra fries were served In Harvey Nichols in both Leeds and Manchester and made an incredible entree to an eight-course tasting menu I created and cooked,” she said.
Asked if there was a drink she recommended to go with the spicy canapes, Freda added: “Fizz! Champagne or Prosecco or a spritzer or cocktail. Although a Mojito is good for a fresh and minty taste on the palette.”
to Amazon bestselling author, awardwinning chef Bobby Geetha blends the heart of Indian cooking with the art of
Canteen and Nesso Coffee in Leeds, he’s put together a tasty snack with plenty of southern Indian spice.
a vibrant vegan canapé that’s quickly become the most popular South Indian tapas-style snack on Kerala Canteen’s
tangy chilli-tamarind glaze. It’s bold, addictive, and perfect for sharing at festive gatherings.
“While not traditionally Christmassy, the warming spices, tangy fruitiness of tamarind, and deep-fried indulgence give it the comforting richness you crave during the festive season,” said Bobby. “It’s also a great meat-free alternative for guests looking for something bold yet plantbased.”
Bobby recommends pairing the dish with a cold pint of Malabar Giant IPA, a draught beer brewed specially for Kerala Canteen. With its light tropical hops and

piece(s) PARTY
Small plates are the way forward this festive season. Here are some great occasion dishes to try at home.
party at Kerala Canteen with prices starting
Adam Harvey is the executive chef at Owston Hall Hotel and has prepared two dishes – one savoury, one sweet.
The nduja, brie and pesto palmier, served and while not traditionally festive it’s
tart is a playful twist on the classic Italian cannoli, transformed into an elegant tart. It brings together the buttery crunch of pastry with a luxuriously smooth caramel cream, delicately laced with a hint of whiskey.
every pint sold supports Yorkshire Wildlife Park — a festive bonus that gives back.
“The warmth of the nduja and richness of the brie make it feel indulgent and special exactly what you want when everyone gathers around,” said Adam, who recommends a glass of pinot noir to go with the dish.
A salted caramel and whiskey cannoli
“I chose this dish because it’s the perfect combination of simple and spectacular,” added Adam. “It’s quick to make but feels indulgent and impressive — ideal for when you want something that looks and tastes like you’ve gone all out, without spending hours in the kitchen. Plus, I’ve always loved the way salted caramel and whiskey pair.”
In true festive style, a deep, fruity port complements the caramel beautifully and enhances the warmth of the whiskey.

Freda Shafi
Spiced Potato & Lamb Puff
Pastry Bites
Ingredients:
2 medium potatoes boiled and cubed (or mashed roughly)
1 clove garlic, minced
½ tsp ginger paste
1 tsp cumin powder
½ tsp garam masala
½ tsp turmeric
½ tsp chilli powder (adjust to taste)
Salt, to taste
Small handful of fresh coriander, chopped
1 tbsp oil or ghee (for frying)
1 egg, beaten (for egg wash) or a little milk if you prefer
Method:
Heat oil in a pan. Add onion, garlic, and ginger. Sauté until golden. Add lamb mince and cook until browned.
Add all the spices, salt, and pepper. Stir well. Mix in the boiled potato and coriander. Let it cool completely.
Roll out puff pastry and cut into squares
Place a spoonful of the lamb-potato or parcels and seal the edges with a fork.

Kerala Canteen Chilli Tamarind Crispy Cauliflower
Ingredients: Serves 4
bite-sized pieces)
Salt – to taste
Oil – for deep frying
or until puffed and golden brown.
¼ tsp Turmeric
½ tsp Baking powder
(adjust for consistency)
½ tsp Salt
2 tbsp Tamarind purée
3 cloves garlic, minced
1
½ tsp Mustard seeds
A few curry leaves (optional)
2 tbsp chopped coriander
Salt – to taste
Method:
1. Blanch the minutes, then shock in cold water. Pat dry thoroughly.
2. In a bowl, mix plain powder.
Whisk in chilled sparkling water slowly to make a light, smooth batter.
3. Heat oil in a deep
batter, let the excess drip off, then deep fry until golden and crispy. ahead and reheat in the oven later.
4. In a pan, heat oil and add mustard seeds. Once they pop, add garlic, onion, green chilli, and tomato. minutes).
Add tamarind purée and sriracha. Cook for 2–3 minutes until it reduces and thickens slightly. Season with salt and stir in chopped coriander.
Just before serving, toss the until evenly coated.
Garnish with extra coriander or toasted sesame if desired.
Owston Hall Hotel Nduja, Brie & Basil Pesto Palmiers with Sticky Onion Relish
Makes 12–16 palmiers
Prep Time: 20 minutes
Cook Time: 25–30 minutes
Ingredients
1 sheet all-butter puff pastry (ready-rolled,
2 tbsp basil pesto Nduja sausage
1 egg, beaten (for egg wash)
2 large red onions, thinly sliced
1 tbsp olive oil
1 tbsp butter
2 tbsp soft brown sugar
2 tbsp balsamic vinegar
A pinch of sea salt
Method:
1. Heat the olive oil and butter in a pan over medium heat.
2. Add the sliced onions and a pinch of stirring often, until soft and beginning to caramelise.
3. Sprinkle over the brown sugar and stir until dissolved.
4. Add the balsamic vinegar and cook for

And
for
1. Lay out the puff pastry sheet on a lightly Spread the basil pesto evenly over the surface.
pastry, then arrange slices of Brie on top.
3. From each long edge, roll the pastry inwards towards the centre so the two rolls meet in the middle (like a scroll).
minutes — this helps it slice cleanly.
2. Line a baking tray with parchment paper.
3. Slice the chilled pastry into 1cm thick leaving space between each one.
4. Brush lightly with beaten egg. up and golden brown.
Serve the warm palmier with a spoonful of sticky onion relish on the side.
something sweeter... Salted Caramel and Whiskey Cannoli Tart


To view this recipe, scan this QR code with your smartphone or visit our website - www.rmcmedia.co.uk
There’s still time to make the most of our Holiday Savings. From gear and components to apparel, find everything you need to elevate your






£22.00
£45.00 Turbo Vado 5.0 Step-Through

£3,499.00
£3,999.00

Men's Softshell Thermal Gloves


RMC bumper CHRISTMAS QUIZ
Test your mettle in our festive brain-teaser.
family and friends and tackle our tricky festive quiz.

1. What is the name of the youngest Crawley daughter in Downton Abbey?
2. What is the pub called in Hollyoaks?

3. Who does the voiceover on Love Island?
4. I Know What You Did Last Summer reboot?
5. The Substance, plays an aging television fitness guru who undergoes a process that lets her de-age. Who plays her youthful counterpart?
6. Who played Scrooge name?
7. The Inbetweeners?
8. In which Christmas Special from 1996 did two lead characters dress up as Batman and Robin to go to a wake?
9. In National Lampoon’s Christmas Vacation plays Chevy Chase’s wife Ellen?
ROUND 2
10. In Peaky Blinders what is the name of the only Shelby sister? 1. Which Black Sabbath frontman passed away in 2025?
Which music and arts festival takes place at the Empire Polo Club in Indio, California?
What was album Mayhem?

Superbowl half-time show in 2026?
What year did Elvis Presley die?
Who won the 2025 Mercury Music Prize?
ROUND 3
GENERAL KNOWLEDGE
1.
Which battle marked the end of the W
ars of the Wa
6. What is the chemical symbol for silver? 5. 4.





ROUND

ia? heir winter tour of Austral t he England cricket team on l captain t Who wil 8. t he decisive winning put Who sank t 7. orld Championships? mostWWo ecorhe r Which Formula 1 driver holds t 6. s singles t s and men’ he women’ Who won t 5. 4. ?decor seconds world r 3.
CU RO FAAIRS
URRENT AFF OUND 4

iterary world The l 3. person? Who overtook Elon 2. isgraced Labour Which d 1.
W 9.
5 the 10. the RO Q7 country Which habetically? ChurholCatch?ic ing game console of al Which popular video game console r
Can W 6. 5. Janu W 4. 0 Whichpopularvideogameco nterbury? by as elin W eplaced Just ho r uary? hich city began its year as U which b anniver tofime?l al eleased its nsole r chbishop of he Ar t e in tur K City of Cul hor? eloved aut h of he birt sary of t th y
OUND 6
HRISTMAS
Which horse won 2. rugby? f ff countries kicked of Which two 1. SPOR In which European country is it 8. ? The Grinch animated version of 7. Christmas advert? 6. the 7th day? welve Days of Christmas Tw The T In 5. ChristmasA 4. 3. 2. alphabetically? teamon ope in for Eur he d for tcor les at itngles t 1. CHRISTMAS ROUND Home Alone In 10. cocktail? 9. meal of 12 dishes on Christmas Eve? traditional to eat a , how many ol Christmas Car


gift guide CHRISTMAS
Get inspiration from the independents this festive season.

A selection of Jellycat soft toys available at ETC Bawtry, Market Place, Bawtry, Doncaster, DN10 6JW. Tel: 01302 714550. www. etcbawtry.co.uk. Facebook: www. facebook.com/ etcbawtry


This Christmas, show your love in the most meaningful way – with the gift of health, healing and serenity. Gift vouchers available for Green Ayurveda Spa www.ayurvedainyorkshire.co.uk

A selection of handbags, purses andn gifts are available at Radley, Lakeside Village, White Rose Way, Doncaster DN4 5PH. lakesidevillage.co.uk


When Life Gives You Lemons, by Hue Folk, £295. Limited 2 Art, 22, 24 Bridgegate, Retford DN22 6AA. limited2art.com


RagBag Studio Lumora Small Studs. A modern take on the classic pearl stud. This earring pairs a bold freshwater pearl on the lobe with a smaller one just below, perfect for both party season and gifting a Morgan Clare, 3 Montpellier Gardens, Harrogate HG1 2TF. Tel: 01423 565709. www.morganclare.co.uk


Icelandic personal fragrances are crafted from plants and minerals found in their wondrous landscape that create scents reminiscent of moments had or dreamed of. North Home, 42-44 County Arcade, Vicar Lane, LS1 6BH. Tel: 0113 345 4880. northhome.uk. Facebook: NorthHomeUK Instagram: northhomeuk



Treat someone special to the charm and elegance of an Owston Hall gift voucher. Owston Lane, Doncaster DN5 0LP. Tel: 01302 722800. owstonhall.com


Festive poinsettia available at Riverside Plants of Shadwell and Linton. Visit

The Savile Row Private Collection captures the spirit of London’s legendary street in six unisex fragrances - Savila, Tela, Sartoria, Bucula, Creatia and Acus, £215 for 100ml. savilerowprivate collection.co.uk



Pre-loved Boodles ‘Palace’ ruby and diamond earrings. RRP £18,000, available for £12,950. Time for Diamonds, 45 Market Place, Bawtry, Doncaster, DN10 6JL. Tel: 01302 710116. timefordiamonds bawtry.co.uk. FB/Insta: timefordiamonds bawtryltd


Specialized Concept Cycles Turbo Vado 5.0 electric bike, £3,499. www.specialized.com


A Treehouse Sleepover: Give the gift of a stay at Treehouse Hotel Manchester — where every room feels like a hideaway. https://treehousemanchester. wearegifted.co.uk/pip-drinking-dining-experience

Shop a selection of luxury watches as Harrogate’s newest boutique. Up North Watches & Jewellery, 39 Parliament Street, Harrogate, HG1 2BU. www.upnorthwatches. co.uk. Instagram: @upnorthwatches / @curtisupnorthwatches




Almost Feeling earrings £99. Wanderlust Stories, 12a Harewood Yard, Leeds, LS17 9LS. www.wanderlust stories.co.uk
Winte W WAARM
Whether you’re dressing to impress or hiberna have you covered. By Ros
his December, your wardrobe should feel like the month itself – luminous, layered, and full of texture.
Whether you’re raising a glass at a holiday soirée, escaping the cold with a mocha in hand, or mastering the art of polished comfort, style this season is all about elegant ease with a touch of indulgence.
But before we dress to impress,
p, let’s look at some winter creature comfortts.
o Mocha browwn
The new neutral this winter. Forget beige- this season’s luxe tone in a rich, velvety hue of mocha brown, that feels both grounding and indulgent.


effffortlessly elevates winter dressing. Mix shades, from light latte knits to dark espresso leather, and pair with ivory, blush, or even a metallic bronze for unexpected warmth.
Perhaps even try out a monochrome mocha moment, a gorgeous headto-toe brown look is this season’s understated power move.
Slouch
Slouchy no longer means sloppy. December’s most modern silhouettes lean into ease with elegance: oversized coats, wide-leg trousers, and
Balance proportions: a roomy or an oversized coat over sleek tailoring. Invest in quality fabrics — wool,
silk blends, and brushed cotton — to keep the look elevated. Finish with sculptural jewellery or pointedtoe boots to ground the softness.







ABOVE: The White Company
funnel neck jumperr, , dark chocolate, £120
LEFT: John Lewis relaxed scoop leather hobo bag, £99




















Baukjen H H B
Hudson
sai
£420 ilor blouse
Clar
Lu ing leopard canvas 90. Morgan Clare
Anine B tote

























Partyw Pa tyweear
A It’s that time of year again! festive party every weekend means one thing: sparklhSh kles everyw sequins loud wi statement piece covered head-to shine, or opt for of partywear. T dresses that glid tailoring in mid metallic accesso Christmassy can champagne, gol where. Shout your th bold, outrageous s like draping dressed -toe in shimmering a more subtle version hink liquid satin slip e as you move, velvet night tone, and beautiful ries that gleam under dlelight. Add some d or silver accents to
ly magnetic.





Gro med top by akesid
Rails goldie top gunmetal,
Sole Bliss Prem her Silver Leat r, , £
£148
£218
l mini al -
MAMU Black St Silk 120 Shorts £75 ess in black, dr
A Calm and LUXURIOUS
Amica celebrates ten years with the launch of a new city centre clinic – and an opening discount.

15 per cent off
For more information, make a booking or to see a full list of services and treatments visit www.amicaaesthetics.co.uk. The clinic is open Monday-Friday from 10am-8pm and Saturday from 9am-6pm.

Situated on the gorgeous Harewood Estate in LS17, we are not your average shop. We like our customers to have a more personal experience and never feel rushed. Come to one of our monthly shopping days or maybe arrange a private shopping evening for you and some family or friends where you can browse and shop in a relaxed environment with a couple of glasses of fizz!
Spot something on our website or socials? DM us to come and try before you buy, we are very flexible in how we work. Please feel free to get in touch!
































































WATCH this space
Up North Watches & Jewellery is now open
diamond jewellery.
imeless and lasting, watches and jewellery make for very popular Christmas gifts and are appreciated for their sentimental value and longevity.
If you’re shopping in Harrogate over the festive period, you’ll want to call into the newly-opened Up North Watches of luxury timepieces as well as soughtafter diamond jewellery such as rings, bzracelets and stud earrings.
Watches will be the main focus at the stylish boutique, which is located on Parliament Street, right in the heart of the spa town. Up North Watches & Jewellery deal in luxury brand timepieces such as Audemars Piguet, Cartier, Patek Philippe, Richard Mille, Rolex and Vacheron Constantin.
Owner Curtis Bitton-Price prides himself on being able to get those hard-
network over the last decade – he can source any watch, big or small, within 24


hours. Thanks to a strong presence on social media, he counts clients from all over the world – from Spain and Belgium to the UAE and USA – and is hoping to add many from Harrogate to that list.


The spa town is somewhere that Curtis knows well. He grew up in Alwoodley, Leeds, attending high school in Harrogate before pursuing a career as a professional footballer.
It was during this time pursuing his sporting dream that Curtis became a luxury watch obsessive and after running a successful events business for over six years, he started trading in these exquisite pieces ten years ago. After largely working
on an appointment-only basis
Leeds, the opening of the new long-held dream.
Curtis has worked with north Leeds-based Amelia Joy Design for the shop design and is delighted to now be able to share it with customers old and new.
“I’ve completely refurbed it from top to bottom and have left no stone unturned,” Curtis said. “It is a real luxury experience and far different from more familiar watch and jewellery stores.”
It’s a stunning space with display cabinets down one side, a small waiting area and a private viewing area on a
“I’ve completely refurbed it from top to bottom and have left no stone unturned. It is a real luxury experience and far different from more familiar watch and jewellery stores.”
“Up North Watches & Jewellery deal in luxury brand timepieces such as Audemars Piguet, Cartier, Patek Philippe, Richard Mille, Rolex and Vacheron Constantin.”
staircase. The palette of mainly dark colours creates a feeling of luxury and is accented by quirky, contemporary artworks.
Watches will take centre stage at the new boutique – they are Curtis’s passion of the aforementioned brands inside.
His favourite brand is Patek Philippe – his day-to-day watch is a 5711/1A, the nickname for which is ‘piano dial’, a glossy, enamel-like white surface with piano keys – but it’s the rare Rolex sports
models that are currently capturing his clients’ attention.
“Anything from steel GMT Master IIs to hard-to-get steel Daytonas and regular stainless steel Date Just models all the way up to your precious metal sports watches, such as solid gold pieces,” Curtis added.
Having launched in 2015, Up North Watches & Jewellery remains a family business and working alongside Curtis is his brother, Remie, both of whom will be on hand to offer any advice and expertise.
The move to retail premises in Harrogate has allowed the business to



stock more in-demand ladies watches too and in the coming months they will also be introducing high-end rare handbags such as those from Hermés and Chanel.
Jewellery will focus on the diamond variety – all
diamonds) – and include a selection of engagement and eternity rings, tennis bracelets as well as earrings. Curtis will beat any price in the Harrogate postcode for all diamond jewellery.
Up North Watches & Jewellery offer bespoke diamond ring and custom jewellery design and to complement the retail services, they have an inhouse watchmaker, boasting 30 years’ experience, offering servicing, repairs and polishing as well as customisation and diamond setting.
The Parliament Street boutique opens Tuesday to Thursday 11am-5pm, Friday 11am-4pm and Saturday 11am-5pm. It will also be opening until 7.30pm on Thursdays in the run-up to Christmas as part of the Harrogate festive campaign.
Up North Watches & Jewellery
39 Parliament Street
Harrogate, HG1 2BU
Tel: 01423 787185 or 07731 138015 www.upnorthwatches.co.uk Instagram: @upnorthwatches

Fenty Beauty high-shimmer gloss stick £23
The buildable lip colour is packed with Squalane, Vitamin E and Shea butter to lock in moisture for up to eight hours, ensuring your lips look nourished and plump.

Charlotte Tilbury Charlotte’s Palette of Beautifying Eye Trends £49
Create limitless, ultra-wearable eye looks with the perfectly nuanced ninepan palettes. Easy to apply, easy to blend and easy to layer, the new.

Amouage Guidance 46 Exceptional
Extrait £425
A new interpretation of the original signature fragrance at a very generous concentration.
Christmas UNWRAPPED
Make sure you’re on top of your beauty gift game with this collection of festive crackers.
Hourglass Illusion luminous glow foundation
£58
This all-inone formula by Hourglass combines of a broadspectrum SPF 30 sunscreen, advanced skincare, and highperformance foundation for an unbelievably luminous glow


LYMA serum and cream starter kit £495
LYMA Skincare sets a new standard formulation bio-engineered with 80:20

Sisley Les Phyto-Ombres No.12 Silky Rose
An eye shadow with a half-powder, half-cream hybrid texture that embellishes the eyes with a veil of colour of radiance.
BEAUTY

Creed Carmina eau de parfum £265
Luscious black cherry and pink pepper bring a contemporary twist to violet and Rose de Mai, while saffron lends a golden warmth.

Dior Forever skin perfect foundation stick £48
Designed to blend with the skin, the soft and light texture of Dior Forever Skin Perfect blends seamlessly for 24h of comfort.

La Mer The Night Recovery concentrate £590
Features a time-release delivery system to accelerate barrier renewal and speed recovery while you rest. This extreme barrier wrap helps speed visible recovery from acute skin

La Prairie Platinum Rare hauterejuvenation face cream £1,425
Powered by a platinum-wrapped multipeptide, this innovative moisturiser improves skin elasticity, evens skin tone, and regenerates essential components.

Yves Saint Laurent Make Me Blush £43
A sensorial silky powder that is comfortable and weightless, blurring the look of pores. This blush doesn’t just colour, it cares.

Bamford Rosemary Willow diffuser
£69.50
The Rosemary Willow Diffuser reveals a crisp herbal blend of rosemary, thyme and lavender with a little clove, geranium and Sicilian lemon essential oils to clear and restore the mind.

Sol de Janeiro Biggie Biggie Beija Flor elasti-cream £82
A moisture-rich body cream that will leave your skin deeply hydrated, soft and resilient to signs of aging.
Tom Ford Gloss luxe £49
The next evolution of lip gloss that goes on light-as-air in sheer-to-medium coverage. Infused with three oils –avocado olive and jojoba.


Loewe Marihuana liquid soap £60
The soap features natural ingredients with skin-nourishing properties and actively hydrating elements including

Skiing andKNEE INJURIES
How to protect your knees on the slopes, by Mr Sanjeev Anand, Consultant Orthopaedic Surgeon (Knees & Sports Injuries).
Ski season is here – crisp air, fresh powder, and the thrill of gliding down the slopes. But as any keen skier knows, it’s not all après-ski and mountain views. Each winter, I see a noticeable rise in knee injuries in my clinic, many of them from the slopes.
Your knees do a lot of hard work while skiing – they twist, absorb shocks, and keep you balanced. It’s no surprise they’re the most commonly injured joint in this sport. The usual culprits are ligament tears (especially the MCL and ACL), meniscus injuries, and occasionally fractures or dislocations. The good news? Most of these can be prevented with some simple preparation and good habits.
How to keep your knees safe this ski season
You don’t need to train like an athlete, but a bit of pre-ski conditioning goes a long way. Strengthen your thighs, glutes, and core – they act as your knee’s natural shock absorbers. Cycling, swimming, squats, lunges, and balance exercises are great ways to prepare.
A few lessons with a professional instructor can make all the difference. Focus on keeping your knees slightly bent and in line with your feet and hips. Try not to lean too far back or twist your knees awkwardly — your quads (and your ligaments) will thank you later.

Secretary: Andrea Kelly 0113 218 5966 andrea.kelly@nhs.net
It might sound strange, but falling safely is it or stick out your arms or legs — this can make things worse. Instead, tuck in your limbs and roll with the fall to spread out the impact.


Secretary: Mrs Amanda Kilner 07787 179878 kneeandsportsurgery@ gmail.com
Secretary: Andrea Kelly 0113 218 5966 andrea.kelly@nhs.net
Joseph Aderinto Hip and knee replacement surgery, primary and revisions
Colin Holton Specialist in young hip conditions including hip arthroscopy, pelvic osteotomies and hip replacements
Sanjeev Anand Knee surgery, sports injuries, paediatric knees and hip arthroscopy
It’s tempting to chase steeper slopes, but Ski within your ability and take breaks before your legs turn to jelly. If you’re tired, call it a day – the mountain will still be there tomorrow.
Soft snow can trap your ski and twist your knee; icy patches can make one ski shoot out faster than the other. Keep your eyes ahead and adjust your speed accordingly.
Make sure your boots and bindings are height, and skill level. Bindings that are too tight might not release during a fall, increasing your risk of injury.
not what you want when hurtling down a slope at speed. Save the celebration for after your last run.
If you do injure your knee
If you feel a sharp pain, instability, or can’t put weight on your leg – stop skiing straight away and get help. Don’t try to “ski through it.” Safely evacuate from the slope and see a doctor as soon as possible. While most ski-related knee injuries can be managed once you’re home, it’s important to protect your joint in the meantime. Use a knee brace and crutches if needed, and apply ice for 15–20 minutes each hour to reduce swelling. Ask your doctor about medication to reduce the risk
Avoid rushing into surgery while your knee is swollen and stiff – that can lead to



“Your knees do a lot of hard work while skiing –they twist, absorb shocks, and keep you balanced. It’s no surprise they’re the most commonly injured joint in this sport.”
complications. Not every ACL tear needs an operation, and many MCL injuries heal well with physiotherapy and rehabilitation. What matters most is getting a proper diagnosis and a plan that’s tailored to your needs.
A knee injury doesn’t just affect your sport – it can change how you move, exercise, and live. Seeing a specialist knee surgeon helps ensure the best possible recovery and gets you back on your feet (and slopes) safely.


Secretary: Dawn Brittain 0113 388 2074 dawn.brittain@
Secretary: Sorelle Hartley 07850 207468 sorelle.hartley@ spirehealthcare.com
Secretary: Viki Short 0113 388 2008 victoria.short3@nhs.net
Mr Sanjeev Anand, MBBS, MS (Orth), DNB (Orth), FRCSI, FRCS (Tr & Orth), DipSEM, PGCert MedEd is a consultant knee surgeon with expertise in sports injuries and complex knee conditions. He treats patients of all ages, including young athletes and children, both in the NHS and privately.
He is the Academic Secretary of the British Orthopaedic Sports Trauma and Arthroscopy Association (BOSTAA) and has contributed to national guidelines on ACL reconstruction, arthroscopic surgery, and kneecap disorders.
His NHS practice is based at Leeds Teaching Hospitals, and he also consults and Spire Leeds Hospital.
For appointments or enquiries, please contact his secretary, Mrs Amanda Kilner, at Kneeandsportsurgery@gmail.com or on 07787 179878.

Campbell F MacEachern Hip and knee replacement surgery, primary and revisions
Veysi T Veysi Hip and knee replacement surgery, primary and revisions
George Whitwell Hip and knee replacement surgery, primary and revisions pp



when you need it TREATMENT
Newmedica provides easier and quicker access to sight-saving treatments.
eople living in and around Harrogate now have easier access to advanced eye care and surgery at Newmedica’s state of the art eye clinic.
Newmedica, located at 2 Grove Park Court, provides pre-assessments for cataracts surgery and oculoplastic procedures for NHS and private patients, with surgery then carried out at the nearby Newmedica surgical centre in Leeds, just 14 miles away. Free transport to and from the clinic is offered to any NHS cataract patients who need it. The new purpose-built clinic also offers YAG laser treatment on site.
Newmedica Harrogate is helping reduce the wait for NHS treatment while offering more patient choice.
Consultant Ophthalmologist David Dunleavy said: “Our aim is to help more people in and around Harrogate access high-quality, affordable treatment when they need it.”
David co-owns Newmedica Leeds and Harrogate alongside three other highly experienced consultant ophthalmologists – Mr Aldrin Khan, Mr Kamran Khan, and Mr David Richards, and operations director Steve Kirk.
He added: “Our Leeds hospital has been operating since 2018, with an excellent reputation for the support it provides to patients and the outcomes they achieve. Being owned and led by the consultants who provide the care means patients are at the heart of every decision. It’s why we offer patients the highest-quality lenses because it leads to the best clinical outcomes.”
from a superior lens as standard, which helps reduce the likelihood of any further treatment being required. As well as leading to better patient outcomes, the use of this lens by Newmedica clinics nationwide has saved the NHS an estimated £4.5million since 2017.
Patients opting to go private have more lens choice, including multifocal lenses which may do away with the need for

Steve Kirk, the operations director and partner of Newmedica in Leeds and Harrogate
reading glasses or toric lenses that help with astigmatism. Newmedica Leeds and Harrogate’s team of ophthalmologists also perform a range of oculoplastic procedures for conditions around the eye, such as drooping eyelids or the removal of lumps.
Steve Kirk, the operations director and partner of Newmedica in Leeds and Harrogate, said: “We know there’s increasing demand for ophthalmic services in and around Harrogate and we’re delighted to help more patients have swifter access to quality care through the new local clinic. Our team is committed to fostering a positive working environment and building strong connections with local optometrists and other healthcare professionals to provide the best possible care to patients.”
Steve has already played an active role within the local eye care community, working as a trustee at the charity Vision Support Harrogate District.
The charity, which was established in 1921, supports visually impaired people in Harrogate, Ripon and the surrounding
district. The charity seeks to enable visually impaired people to live independently, while also providing opportunities to meet and interact with other visually impaired people.
The Newmedica clinic is also helping to train tomorrow’s eye surgeons as part of an initiative aimed at easing the NHS’s backlog. This is part of an agreement between independent healthcare providers and the NHS to ensure medical trainees have new opportunities to train in elective surgery or diagnostic activities in the independent sector.
For more information, visit newmedica.co.uk/clinics/harrogate or call 01423 223219.

Back-to-back WINNERS
The Peacock at Rowsley grabbed the headlines but with 26 awards in total, there was lots to celebrate at our annaul restaurant and bar awards, sponsored by The Owlerton Experience, writes Richard Abbey.



Our sister magazines, Westside and Southside, returned to Bar Awards.
Southside readership area, meaning a prizes.
independent eateries found in our region









g d Café/Lig ld f h fé l ht Bite dButchersCaf TheO he Ol chhe afféé&Biistro

Dining Pub e&HoundsFishla Ha Haar r Hoound sh ak k ke e


ftern l h oon T A Af f Teea sStraw
things fresh.
I Inndian a’sTicZaarra’’s ckkhill
ThheeGlas Straawwbberry

Kerala Canteen Set Menu
Kerala Canteen Set Menu – just £19.75
Looking for a flavour-packed food journey through South India? Enjoy our Kerala Canteen Set Menu – perfect for lunchtime, casual dining, or a pre-theatre treat. For just £19.75 per person, you can mix and match your favourites:
Pick one of each:
• One Tapas Plate • One Wholesome Bowl
• One Signature Side • One House Dessert
This is the ultimate way to sample our bold Kerala flavors at incredible value – perfect for first-timers or regulars looking to explore something new.


5 St. Peter's St, Leeds, LS9 8AQ 0113 873 0635 info@keralacanteen.com


























eatured in the newspaper as one of the top 20 afternoon teas in the country, alongside The Ritz and Fortnum & Mason, The Glass Strawberry’s superb selection is simply stunning. Enjoy a cornucopia of delicious treats in this contemporary and funky city centre












Hand-crafted wooden stands, decorated with seasonal fl blossoms or other holiday




as well as fresh-baked cinnamon fruit scones, made to a 40 year old recipe. Preceded by the chef’s taster of homemade soup, all served alongside pots of Yorkshire tea or coffee, with Prosecco or cocktails on hand if the occasions demands it.

No wonder people travel from all over the country — with orders from as far as Australia and Canada — for families to treat their loved ones.
























































































Hidden away in the quiet, picturesque village of Sinnington,set on the edge of the beautiful North York Moors, just a short drive away is the renowned market town of Helmsley and the delightful village of Thornton le Dale, well known for Mathewsons Auctions Bangers and Cash!
The F&H is a romantic 18th Century Coaching Inn with rooms, and delicious food served in our cosy restaurant, Lounge Bar or our dog friendly bar. Relax in style away from the madding crowd. We have 14 lovely en-suite bedrooms, plenty of space to relax and enjoy the peace and quiet in the countryside. Comfortable and welcoming with lunch and dinner served daily. The cosy lounge bar and our restaurant offer the highest quality food and drinks. We proudly host meetups for small driving clubs, with private parking and stunning Moor driving roads to offer them.

SHOWTIME

Last few tables available for:


Tameka Jackson as Diana Ross
Tameka has been captivating audiences around the world for years with her stunning tribute to Diana Ross. From the soulful sounds of Motown to the glamour of the stage, she brings the essence of a true legend to life.



All of the Latin artists everyone knows and loves in ONE HUGE NIGHT! Non-stop 90's Latin hits in one electrifying night of fun! The ultimate 90's latin pop including Jlo, Shakira, Gloria Estefan, Ricky Martin.

Anyone for SECONDS?
Italian-inspired brunch afternoon tea is a unique concept but is one that is done particularly well at the new Leeds city centre Nesso Coffee, writes Ross Heppenstall.
esso Coffee, the independent Italian-inspired brunch and afternoon tea venue created by award-winning Leeds chef Bobby Geetha, recently opened its second site in the heart of Leeds city centre.
Nesso has already gained a cult following in Morley for its creative twist on traditional Italian café culture and a stunning menu which brings bold Italian approachable offering.
The cosy establishment on the outskirts of Leeds opened in October 2023 with the aim of offering something new to the residents of the historic market town.
So successful has Nesso been in Morley that the bold decision was taken to open up a second, larger site, in the centre of Leeds.
Already it looks a very shrewd move with its many rave reviews testament to its growing popularity.
Whether you are in Leeds for a relaxed brunch, a business meeting, or a romantic date, Nesso offers a warm and welcoming space.
The menu was designed by renowned Leeds restaurateur and MasterChef UK consultant Geetha, who was brought on board as a consultant chef.
From training at the three Michelinstarred Noma in Denmark to working in Dubai, where he was named United Arab Emirates’ Best Indian Chef in 2018, Gheeta’s CV is impressive to say the least.
Location-wise, Nesso Leeds is perfect. Situated on the bustling Merrion Street, at the top end of town, it is a stone’s throw from the nearby Grand Theatre, Howard Assembly Room and First Direct Arena with plenty of parking available at the Merrion Centre.
Open daily from early morning until evening, Nesso is somewhere you can go for breakfast, brunch, coffee, lunch, afternoon tea or dinner and drinks before heading to the theatre or a gig.
Named after the village in Lake Como, Nesso Coffee in Leeds serves authentic Italian food and builds on the success,





passion and excellence of their Morley a day-to-night menu packed with Italian delicacies.
All day brunch favourites include breakfast hash, eggs purgatory, baked falafel, pulled duck and egg hash, smoked salmon avo toast, baked meatballs, french toast made with panettone, mini pancakes, focaccia marinara, breakfast baps and crostones – an Italian open cheese toastie.
Ingredients are sourced from Italy, for an authentic and delicious food experience.
Nesso pride themselves on being a Yorkshire independent café with a squeeze
My dining partner and I went for Nesso Brunch Afternoon Tea at lunchtime and it is an absolute treat.
Priced at £39.95, this includes a wide range of offerings and you can choose one focaccia pizza to share or any two brunch dishes from those listed above.
I was tempted to go for the baked meatballs, smothered in rich marinara sauce, jalapeno infused with garlic butter and pesto, served with olive focaccia bread and a sprinkle of parmesan cheese.
The Eggs Purgatory were also very
tantalising, but in the end I went for the breakfast hash, which was delicious.
This dish contains meatballs baked in Italian tomato sauce with hash brown,
with hollandaise sauce and accompanied by toasted Pugliese bread.
My partner went for the French toast/ pancake, which is a toasted panettone or mini butter pancakes with berry compote, maple, Biscoff and a soft-serve cone.
The Nesso Brunch Afternoon Tea also includes two baked giant scones, clotted cream and jam, two cupcakes, two pistachio cannoli and two hazelnut cannoli.
Drinks-wise, there is a pot of tea or a cup of Americano coffee, plus two creams on a
To top this delightful meal off perfectly, also included is a 175ml glass of prosecco each.
The price for two people – at less than £20 per person – represents incredible value and in such a delightful venue too.
For those with a sweet tooth, there are fabulous desserts and Nesso’s drinks menu showcases 100 per cent single-origin Arabica coffee, along with speciality lattes such as Japanese Matcha, Iced Purple Ube,
and the Instagram-favourite Beetroot Latte.
The café also serves bubble tea, smoothies, Italian wines, beers, and signature spritz cocktails.
Their carefully selected Italian wines, Birra Moretti, and craft cocktails make Nesso the perfect brunch-to-bar destination.
The two sites in Morley and Leeds city centre are the only Yorkshire cafes offering an innovative Brunch Afternoon Tea featuring prosecco, giant baked scones, cupcakes, pistachio and hazelnut cannolis, focaccia pizza or brunch dish, tea or coffee,
can be added extra.
The staff are lovely and welcoming and it was a bonus to be able to meet Geetha, the brains behind the whole Nesso operation, and chat to him about his growing empire.
This new city-centre venue is a homeaway-from-home, bringing their signature brunch, coffee culture and wine-bar vibe to the heart of Leeds. I look forward to visiting again soon.
Nesso Coffee Leeds
42 Merrion Street, Leeds LS2 8JG, nessoleeds@gmail.com nesso.coffee/


Monday–Thursday 2nd January–31st January 2026
Taste the essence OF INDIA

Renowned Dubai restaurant brand India Bistro makes its UK debut in Leeds.
Amuch-loved Dubai dining brand Leeds.
The UAE and India-based restaurant
Allerton and is a vibrant destination with authentic Indian dishes and bold cocktails all infused with modern innovation.
From the bustling lanes of Delhi and Punjab to the royal kitchens of Awadh,




India Bistro celebrates iconic regional dishes from North India and beyond, crafted by highly skilled chefs using the freshest ingredients and a touch of
With four established restaurants - two in Dubai and two in India - India Bistro has
curated all day menu designed to offer a
iconic Indian dishes and local favourites in a modern, elegant setting.
Signature dishes include aromatic kebabs like the Gosht Seekh Kebab, tender
and tandoori roti.
The bar is designed as a journey in
of Rajasthan, Gujarat and Goa and an commitment to high-quality, globally
The interior design of the restaurant is
everything from intimate gatherings to lively social moments.
Tadka, and freshly baked offerings such as





Step into Manchester’sPLAYGROUND
The Treehouse Manchester hits new heights for hotel stays, writes Richard Abbey.
As much as we like to champion the wonderfulness of Leeds and Harrogate and the Yorkshire region, sometimes you can’t help but
living in our area, the short hop across the Pennines to Manchester is one that is made on a frequent basis.
Whether you’re visiting for the shopping, the live music or for sporting endeavours, the modern metropolis has a constant buzz that proves so attractive to visitors. And with the opening of the Christmas markets, that trip just got a whole lot more attractive.
I’ve stayed in Manchester on a number of occasions in a variety of different hotels and after a while they all seem to merge into one. Rooms frequently have that same neutral décor that while pleasant can be a little bland.
The same can’t be said for the Treehouse Hotel, which opened in the city in March and brings a big dose of fun and colour to the city – and it’s conveniently located just off Deansgate next to Harvey Nichols and the main shopping areas.
Treehouse is the latest brand from Starwood Hotels – their only other UK hotel is in London – and was founded on

the ideas that inspire a child to build a treehouse. Adventure, independence, cozy spaces and repurposing crafty things are what make a place warm and special.
Arriving on a dark, wet autumn evening it was hard to fully appreciate this concept from the outside, but step inside and that all changes. I can only liken it to stepping into a Disney resort hotel. The décor is

and natural materials complemented by a bold colour scheme.
Joining the reception on the ground
later – and the Knick-Knacks shop, which sells a charming collection of locally crafted goods, artisan treasures, and unique curiosities.
The fun element at Treehouse Manchester is enhanced even further with the addition of The Playground gym, Flix screening room and guests can use the two padel courts at the adjoining Pollen Club next door. There’s more to come too – a 14th
new year, providing fantastic drinks and panoramic views over the city.
Once checked in, I headed up to my a real juxtaposition of styles with exposed concrete ceilings and wiring complemented by wooden shingle tiled walls and roughly plastered walls painted in warming hues. A patchwork quilt adorned the super king size bed along with an assortment of cushions in a variety of colours and textures.
With a separate seating area and workspace there was plenty of room to relax with a HD smart TV and bedside USB outlets adding modern touches and
The green-tiled bathroom had a walk-in rain shower as well as custom toiletries and complementary robes.
Suitably refreshed, I headed back down to the restaurant for my 8pm dinner reservation. Pip is headed up by Manchester chef Mary-Ellen McTague and serves an all-day menu focusing on utilising local, seasonal produce from sustainable sources. It has already been added to the Michelin guide and recently won the Leading Restaurant of the Year 2025 at the This is Manchester Awards.
I was impressed by the seasonal selection of dishes on offer and after starting with a bread plate (£6) – the accompanying beef dripping and homemade butter were delightful – tucked into a comforting autumn dish. Lyme Park venison pudding (£28) was a nod to the type of dishes grandma used to make and was rich and warming and elevated even further by a stunning juniper and red wine sauce, which paired beautifully with the celeriac puree and buttered greens.
A glass of El Renegado Bobal (£10 for 175ml) had plenty of body to match the
The restaurant is a relaxed space and continues the quirky theme of the hotel with birch trees, rope, tiles and stained



glass windows as well as lots of foliage hanging from the ceiling.
the most delicious Earl Grey Tea cream (£9) and an Irish coffee (£10) before heading back up to my room.
Breakfast is also served in Pip and provides the perfect pick-me-up to start your day. Coffee, fruit juice, yoghurt and granola and a Treehouse English breakfast
put a spring in my step before I had to head



back to the train station for that return trip over the Pennines.
something new to the table and is all the better for it. Why would you settle for bland and boring?
Treehouse Manchester Blackfriars Street
Tel: 0161 553 0055
www.treehousehotels.com/manchester
Forget about the HANGOVER
Travelling is a given for many of us this festive period, whether you’re visiting family, friends or just looking to get away and enjoy some peace and quiet.
Christmas, and the run up to it, is a time alcoholic variety. And whether you’re the designated driver or someone who doesn’t like or partake in alcoholic drinks, this doesn’t mean you’re solely limited to soft ones.
With a growing generation of people that are foregoing alcohol, drinks manufacturers, especially in the alcohol industry, have had to get creative to meet an ever-changing market. Hence the rise in low-alcohol and non-alcoholic drinks.
you’ve noticed the growing shelf space in supermarkets for these alternative drinks.
Wines in particular have come on leaps and whites to pinks and sparkling.
Non-alcoholic wine is wine that has had its alcohol removed or is a wine-like
Most high-quality non-alcoholic wines are created through a careful dealcoholisation process applied to fully fermented, traditional wine. This approach aims to
aroma, and mouthfeel.
The taste of non-alcoholic wine varies widely and differs from traditional wine,
wine and can sometimes taste sweeter, as
some unfermented grape sugars remain. Modern producers use sophisticated acidity.
alcoholic wines are often lower in calories; for example, a 150ml glass can contain as few as 15-50 calories, compared to over 100 in traditional wine. And the primary advantage is that it completely reduces Christmas parties stack up one after the other.
With this increase in non-alcoholic wines, we thought we’d put them to the test and so approached several leading supermarkets as well as some local suppliers for some samples. We sourced sparkling, with prices ranging from £2.99 to £14.
We started with the white wines, a

pinot grigio from Majestic Wine. The and ‘unpleasant aftertaste’. The other two rating them as ‘refreshing’ and ‘tangy’; ‘fruitier’.
had an average score of 19 out of 30 with our panel agreed that it didn’t taste like a red wine. over 20 out of 30. Our highest scorer (25 out of 30) was the Cordorniu Zero Rosé from Waitrose with our panel loving the refreshing and not too sweet’, ‘good all-
Giving it a run for its money was the alcohol free, also from Waitrose and the ¡H! Barcelona Hola alcohol free sparkling from good. Our panel also felt that the Costellore Zerozecco from Aldi provided fantastic
To summarise, our panel felt that these particular, provided a fantastic alternative at stocking up on a few of these to keep in the fridge over Christmas.



Alcohol Free A Avvera
TESCO
Sauvignon Blanc Blush
£3.50 age score: 16/30





MAJ Moderato Révolutionn A Avvera
JESTIC WINES o Colombard Cuvée naire 0.5%, France £14 age score: 21/30



LAITHWWAAITES
¡H! Barcelona Hola alcohol free sparkling £5.99 A Avverage score: 22/30


SAINSBURRYY’S
McGuigan Zero Alcohol Free Shiraz Wine Based Drink £4 A Avverage score: 19/30 ALDI erozecco Sparkling White £2.99 ge score: 20/30
Costellore Z W A Avverag

W WAAITROSE
Thomson & Scott NoughtySparkling Rose Alcohol Free Wine £9.95 A Avverage score: 24/30
And the winner is
winner made it a very good evening for W




REAL Blush N Ro A Avverag WAAITROSE on-Alcoholic Sparkling se £11.50 ge score: 22/30
aitrose, who also took Wa
second and (joint) third spot, the latter alongside Laithwaites
Our panel felt that the sparkling rose was the nearest thing alternative.’
average score of 25 out of 30. and ‘great price, nice taste’. refreshing’, ‘smooth aftertaste’ , the taste. Comments included ‘light and colour and, ultimately


Going beyond RUGBY LEAGUE
Whether you’re looking to experience the matchday atmosphere or want a superb space for a special occasion, the facilities at AMT Headingley Rugby Stadium are second to none.
eadingley has to be one of the most unique stadium complexes in the country. Comprising two separate grounds – Headingley Cricket Ground and AMT Headingley Rugby Stadium – it provides visitors with the perfect base from which to enjoy the best of both sports and lots more besides.
There has been a stadium in Headingley since 1889, when Leeds Rhinos (then called Leeds St Johns) built Headingley Stadium.
1890 when Leeds CC played Scarborough CC. Since then, the stadium has hosted international rugby and cricket, including the Rugby League World Cup Final in 1970 and the Ashes series in 1981.
Lots has changed since that time.
The £45million re-development of Headingley Stadium in 2019 was the
most exciting and highly anticipated improvement in over a century. This brought a new architectural landmark to the city as well as world-class facilities for Leeds Rhinos, Yorkshire County Cricket Club and Yorkshire Carnegie.
At the heart of this and connecting the two stadia are hospitality facilities comprising eight suites, 15 meeting rooms and 36 hotels rooms, which fall under the umbrella of Headingley Stadium Events.
The jewel in the crown of these suites is the Howard Suite, which can accommodate 450 people and offers views of both windows. On Rhinos matchdays the suite is an amazing corporate hospitality facility, buzzing with Leeds Rhinos sponsors and hospitality guests; businesses entertaining clients, friends and family getting together
entertaining Super League rugby as well as
“I wish we could bottle the matchday atmosphere, there’s nothing like it,” said Lucy Hetherington, business development manager at Leeds Rhinos. “But it’s more than just a match, in fact you don’t have to be a rugby fan to appreciate these fantastic facilities and the whole package. We provide a full customer experience – I always say, once you’ve been through the gates you’ll want to come again and again, everyone is welcome and everyone is made to feel very welcome.”
The hospitality and catering at Headingley Stadium Events is provided by Sodexo Live! a global leader in sustainable food and valued experiences. Their provision runs far beyond matchdays so

whether you’re planning a high-impact conference, a stylish gala dinner, or an intimate celebration, Sodexo Live! deliver bespoke solutions tailored to your vision. With panoramic views of the pitch, state-
from board meetings to large-scale exhibitions.
A dedicated onsite sales and marketing team works closely with clients to ensure every detail is considered, from creative concepts and branding opportunities to seamless logistics and catering. Sodexo Live! prides itself on a collaborative approach, drawing on the energy of match days and the prestige of the stadium to elevate every event.
Sodexo Live! bring hospitality excellence and sustainability to the forefront, offering locally sourced menus and eco-conscious practices. Whether you’re hosting guests from Leeds or beyond, Headingley Stadium Events promises a memorable experience rooted in professionalism, passion, and place.


Leeds Rhinos Foundation
Celebrating its 20th anniversary this year, the Leeds Rhinos Foundation was established with the purpose of ‘changing lives through the power of sport’.
In that time it has become a well-respected charity delivering projects in the heart of communities that provide opportunities, raise aspirations and enable people to be the best they can be.
Values are based around four pillars:
• TRUST to be trusted by everyone they work with to deliver excellence.
• ENJOYMENT create a positive environment to inspire everyone they work with.
• PROGRESSIVE are forward thinking and innovative
• INCLUSIVE fairly, with dignity and respect and do not discriminate.
“When we took ownership of the Leeds Rhinos in 1996 one of our four objectives was to be more connected with the city of Leeds and beyond,” said outgoing CEO even bigger impact, we formed the Foundation in 2005.
Foundation is now doing is quite remarkable, so many people services. But we always want to do more, so we continue to support the Foundation to enable sport to
www.leedsrhinosfoundation.org
AMT Headingley Rugby Stadium
St Michael’s Lane, Headingley Leeds LS6 3BR
Tel: 0344 248 6651 headingleystadium.events

levate your stay in Sliema, Malta’s stunning coastal gem, at the exclusive Best View Luxury Fortina Suites. Offering a selection of elegantly appointed one, two, and threebedroom suites, each designed to provide the utmost in comfort and sophistication, the stunning development will ensure that your experience is nothing short of exceptional.
Offering an unparalleled blend of luxury, comfort and convenience, Best View Luxury Fortina Suites is the perfect choice for discerning residents. Every suite features en-suite bathrooms, combining modern aesthetics with high-end amenities to create a relaxing haven. Guests can
and state-of-the-art technology, all while basking in the spectacular views that make the location truly unique.
shopping, dining and cultural experiences. Just a short ferry ride to Valletta, you’ll be perfectly positioned to explore the island’s rich history and charm while enjoying the convenience of Sliema’s vibrant community.
With expansive windows and private balconies, you’ll experience the beauty of the capital’s fortresses, pulsating harbours and grand architecture every day. The unobstructed views create an awe-inspiring backdrop that makes every moment extraordinary.
At Best View Luxury Fortina Suites, staff pride themselves on providing unparalleled service with a 24-hour concierge to cater to your every need. The dedicated team can do everything from arranging transportation to providing tailored recommendations.
At Best View Luxury Fortina Suites, guests enjoy access to stunning indoor and outdoor pools, a rejuvenating spa, and a state-of-the-art gym designed to keep you
Indulge your palate at the exquisite restaurants, Tora and Manta, where you can savour culinary masterpieces while soaking in breathtaking surroundings.
Experience Asian fusion like never before at Tora, where traditional techniques can sample high-quality Mediterranean cuisine where local ingredients and creative you’ll savour every time.
Unparalleled LUXURY
Discover Best View Luxury Fortina Suites, Sliema, Malta.











Breathtaking views, SUPERB SERVICE
In partnership with Star Ferry, the legendary Peninsula Hong Kong has brought back

Sunset Cocktail Cruise
ighly popular sunset cocktail and afternoon tea cruises from The Peninsula Hong Kong have returned for autumn 2025.
Having enjoyed unprecedented popularity since their launch in early 2023, these voyages have brought a fresh twist to The Peninsula’s beloved tradition of Afternoon Tea, as well as the enjoyment of early-evening cocktails.
The cruises, which provide guests with breathtaking views over Victoria Harbour and Hong Kong Island, will once again be hosted aboard the World Star ferry – an elegantly customised Star Ferry dedicated
Kong’s most iconic and venerable brands: The Peninsula Hong Kong, which for 97 years has been renowned as the city’s iconic Grande Dame; and Star Ferry, whose boats have plied Hong Kong’s waters for 126 years.
The Afternoon Tea journeys are offered twice daily every Saturday until 31 January 2026, and launch from the Tsim Sha Tsui pier, cruising a 105-minute route that takes Cultural District, Stonecutters Bridge, and many other sights.
Along the way, guests aboard the World Star ferry are treated to a welcome drink of refreshing The Peninsula Sparkling Tea, enjoy music from a live jazz band, and culinary delights from a splendid new Afternoon Tea menu.
Savoury choices include Seaweed
Soya Sauce; Pulled Smoky Pork with Sauerkraut Slider; White Tuna with Capsicum and Olive Puffs; and Roasted
and Classic Cucumber Sandwiches.
Sweet treats include Pineapple Coconut Cake; Rice Pudding Tart with Vanilla
Basil Curd; Dark Chocolate Ganache and Pistachio Streusel, and signature Raisin Scones with Clotted Cream and Strawberry Jam.
A selection of proprietary Peninsula Teas, coffee and herbal infusions are also offered.
The Peninsula Hong Kong also offer lively and indulgent Sunset Cocktail Cruises on selected Friday evenings monthly from Hong Kong Island’ s Central Pier 7. Once aboard the World Star ferry, guests enjoy mood-setting music from a rotating cast
including beer, Prosecco, and signature cocktails. They can also savour delectable



Gelée; Chocolate Tart with Hazelnut Praline, and more.
The Afternoon Tea cruises are priced at HK$ 820* per person (equivalent to around £80) and embark from Tsim Sha Tsui pier on every Saturday from 1pm to 2.45pm and from 4pm to 5.45pm. The Sunset Cocktail Cruises embark from Hong Kong Island’s Central Pier 7 at 6.30pm and return at 8.15pm on selected Fridays until 30 January 2026. They are also priced HK$ 820* (*Prices are subject to 10 per cent service charge).
The Peninsula Hotels group has a unique identity among the world’s leading hotels. Established in 1928, it now operates
Kong, plus Shanghai, Beijing, Tokyo, New
The Peninsula Hong Kong opened her
1928 and has been welcoming guests and patrons from all over the world in true

Peninsula fashion ever since.
The hotel prides itself on having the highest staff-to-guest ratio, one of the lowest staff turnover rates and some of the longestserving employees of any hotel in Hong Kong.
Throughout the years, The Peninsula Hong Kong has been the recipient of countless awards and accolades from leading international and local print and online publications, travel guides and more, cementing her reputation as one of the
Reservations for both The Peninsula Afternoon Tea on the Harbour and Sunset Cocktail Cruises can be made online via The Peninsula eShop: offers/ dining/the-peninsula-afternoon-tea-onthe-harbourenquiries, or by email at diningphk@peninsula.com

Live DJ
Deck the HALLS
Nothing gets you in the festive spirit quite like decorating the Christmas tree. Maybe you love unusual baubles or perhaps you prefer something a little more extravagant? Either way, we’ve put together a collection of Christmas tree decorations so you can create a look that’s as unique as you are.
















1 Ribbed glass Christmas tree shaped canddle £3wwwpoundlandcouk 2 Embroidered ‘G&T’ can Ch kingtables.co.uk £3. www.poundland.co.uk G&T can Christmas with a beaded outline and green bead details. Finished with a pink cord loop and silver coloured back, £8.50. www.oliverbonas. com 3 Olive leaves embossed bauble £1.50. www.dunelm.com 4 Noel embroidered Christmas cushion, £25. www.coxandcox. co.uk 5 Collection of three festive Starlights in striking red and green, £45. https://paperstarlights.com 6 Nutcracker Christmas dinner candles - two pack, £12. www.tal k 7 A beautiful large pre-lit 60cm wreath that you can decorate as much le as you fancy or as litt y, , £69 95. https://sparkle.lighting 8 Traditional glass baubles in a contemporary colourway (set of four) £20. www.dunelm.com 9 www.poundland.co.uk 10 Very Noel lit room sign Christmas decoration £15.99. very.co.uk
hristmas tree decoration





















11 Sustainable paper decorations available in a ee topper star tr r, , £40. www.gardentrading.co.uk hanging decoration £3.50. www.dunelm.com 1 hanging decoration £1. www.poundland.co.uk h music £22.99. very rotating house scene wit y..c www.rowenhomes.com 21 esin W White r Weest H
Christmas tree decoration £22. www.rockettstg range of colours and designs at B&Q wwwdiycom 12 Cante ge.co.uk james.co.uk james.co.uk o.uk k .matalan.co.uk k B&Q. Canterbury 13 Matalan ‘Merry & bright’ cushion £15. www k 14 Dunelm beaded magic 5 www.sophieallport.com 16 White polar bears wooden 17 ly T W John Lewis Woorld Trreasures. alphabet stocking, £20. www.johnlewis.com 18 V Veery k 19 Roshani star baubles (set of two), £22.50. nkuku.com 20 Christmas tree cushion. Highland T Teerrier bauble, £8.95. www.annabel k 22 Faberge style opening red www.annabel k 23 Large antique gold dove geor k 24 Sophie Robinson three prism folding paper trees £16. www.dunelm.com
erbury mirrored Christmas












tradition yet Brightest CHRISTMAS
Experience RHS Glow at RHS Garden Harlow Carr.
As twilight falls, on selected dates from
Carr in Harrogate will transform into a world of magical winter wonders where you can admire

in a whole new light - illuminated by thousands of glittering lights. friends and family and explore a familiar place in a whole new
off the start of the festive season in a beautiful and atmospheric setting. Explore the breath-taking beauty of the RHS garden as amazing illuminations light your way along a spectacular trail.
landscapes now shimmering with festive brilliance. Discover new surprises at every turn, with hidden vistas bathed in soft glows and

bold beams, creating a magical, atmospheric journey like never before. Experience a mesmerising display of light and colour, from brilliant hues to the breathtaking Thaliana Bridge lit up to reveal its striking architectural beauty and
Take a break along the way and tuck into tasty festive treats and warming drinks available to buy. Enjoy a mulled wine or indulgent hot chocolate and choose from a tempting range of
Harrogate Arms and savour a delicious selection of Bratwurst and jacket potatoes, or warm yourself while toasting marshmallows
You can even do a spot of Christmas shopping before you huge selection of Christmas trees and plants to unique gifts and bring the magic home.
RHS Glow runs from 4.30-8.30pm on selected dates from 19 November to 23 December with last entry 7.15pm - book now to secure the date and time of your choice!

In addition to selling a fabulous range of bedding plants and perennials, we also stock a wide range of container grown trees and shrubs plus a selection of popular composts, bark and other gardening accessories.
Monday to Saturday: 10am - 4pm Sunday 10am - 2pm (May & June)
• Quality, Home Grown, Seasonal Bedding Plants
• Great range of Perennials
• Container Grown Shrubs and Trees
• Roses
• Hanging Baskets and Ready planted patio containers
• Fantastic range of ceramic Patio Pots
• Compost, Bark and Manure



Give a gift that lasts this CHRISTMAS
Write a Will for your family, by Lindsey Rawson Wills, Trusts & Probate Solicitor and Director at Howells Solicitors.
As Christmas approaches, many of us focus on giving, gathering, and creating lasting memories with loved ones. But Christmas also offers a
wish to leave behind. Amid the sparkle and sentimentality, it’s an ideal time to consider writing or updating your Will.
Will writing may not seem festive, but it’s one of the most meaningful gifts you can give your family. It provides clarity, security, and peace of mind, ensuring your wishes are honoured and your loved ones are cared for. Whether it’s passing down
support, or leaving a charitable donation, a Will allows you to express your values and affection in a lasting way.
Gifting through a Will can be deeply personal. You might choose to leave a
grandchild funds for education, gift a family home to a sibling, or ensure a lifelong friend receives something special. These gestures, planned thoughtfully, can become cherished legacies.
Christmas is a time of connection
conversation with your family about your intentions? It’s not morbid; it’s responsible and loving. And with professional legal guidance, the process can be straightforward and empowering.
So, this year, alongside the mince pies and mistletoe, consider giving the gift of certainty. A well-crafted Will is more than that echoes long after the decorations are packed away.
peace of mind. Speak to our approachable

team about writing your Will, exploring gifting options, setting up Trusts, arranging Lasting Powers of Attorney, and preparing for inheritance tax.
Call us today on 0114 2743 481 or visit www.howells.law to get started.
Howells Solicitors
Rotherham and Regent Street Barnsley

AUTUMN
Give your interior a new look. These local businesses provide plenty of expertise and creative ideas.

Coldbath Flooring provide an extensive range of wood conscientious customer service to ensure that you are 135 Cold Bath Road, Harrogate, HG2 0NU. Tel: 01423


Vienna - Moldau Acacia bedroom available at Buywell Interiors Ltd, Unit 155, Avenue B, Thorp Arch Estate, Wetherby, LS23 7BJ. Tel: 01937 844288. www.buywellinteriors.co.uk
Good furniture and decor lasts, but also gives lasting pleasure.
North Home, 42-44 County Arcade, Leeds LS1 6BH. Tel: 0113 345 4880. northhome.uk

Ultimate Bathrooms, Unit 3E Aven Industrial Park, Tickhill Road, Maltby, Rotherham, S66 7QR. Tel: 01709 811404. www.ultimatebathrooms.co.uk

The White Company Felt Pumpkin Decorations – Set of 6 £15. www.thewhitecompany.com











Always Great Deals on BIG BRANDS








here’s something quietly heartbreaking about the
mountain of throwaway gifts that appear every December. The novelty mug that cracks before Y New Yeear ’s, the gadget destined for the back of a drawer. They never felt good to give, and these days they feel worse. The environmental impact of our throwaway habits is too visible to ignore, and nobody wants to add to the pile.
The heart of a thoughtful gift isn’t in t somethin decoratio a mug th for winte
So thi cute. Th with the don’t sh


he price or the size; it’s in the intention. It’s choosing g you know will be used, loved, and still around when the A ns come down. favourite candle that scents their home, at becomes part of their morning ritual, a blanket that lasts rs to come: small things that make life feel a little richer. s Christmas, pause before reaching for the quick or the ink about what’s truly worth having around, and give hope that it’ll stay a while. Because the best presents out; they stay.


Coldbath Flooring
Wood Flooring
• Modern showroom displaying carpets, wood flooring, luxury vinyl plank and tiles.
• Specialising in oak flooring planks, and herringbone with an enormous collection to choose from.
• Excellent informative showroom service and assured fitting.
• Offering a large collection of carpet runners for staircases with taped boarders and stairrods.
• Bespoke rug service from Jacaranda, Crucial Trading and Alternative Flooring.






















Resin Bound
Decorative Surface Dressing Systems
We are a family run business with over 25 years’ experience that always provide a personal and bespoke service to breathe new life into tired paths, driveways and hard areas.
Our products have been used on Drives, Paths, Patios, Roads and Parking areas in both the private and public sectors.
Resin bound surfacing is an exciting alternative for your driveways, decorative patio area and pathways.
With a smoother profile texture appearance than a resin bonded surface, this coating is also available in many different sizes and colours to suit your decorative requirements. The aggregate material is mixed with a suitable compound and laid on the prepared surface min 15mm in depth to provide a smooth and aesthetically pleasing bound surface.
Simply rejuvenate your drive or patio areas or even create new ones.
Resin bound systems are also permeable – they allow surface water to drain through complying with Sustainable Urban Drainage Systems (SUDS)
Resin Bound Dressing
An exciting alternative for your driveways, decorative patio area & tree pits.
Artificial Grass, Fencing, Steps and Ramps now available. Book to view our new display area.



For over 50 years Ronacrete has been at the leading edge of product development and performance. They provide a specialist range of products for installation by expert contractors such as ourselves.
To ensure that all our customers get the best possible service and highest quality product all of Ronacrete materials are manufactured to a quality management system and are certified to BS EN ISO 9001:2008





















LUKE 1977 menswear launches at Lakeside Village
Lakeside Village is excited to welcome a new menswear store, LUKE 1977, bringing contemporary fashion and style to the Doncaster based popular outlet shopping destination.

The new store opened its doors on November 7 offering a blend of British heritage with modern design. Built on a philosophy of function meets fashion, LUKE combines technical innovation with everyday wearability
“We’re thrilled to welcome LUKE 1977 to Lakeside Village,” said Lyndsey Parry, centre manager. “The brand’s unique style and strong following make it a fantastic addition to our retail mix offering everything from comfortable joggers to waterproof coats and jackets that won’t break the bank. We’re always looking to bring fresh and exciting options to our visitors, and LUKE delivers just that.”
Home of British designer streetwear, terrace wear, smart casual wear and highly anticipated co-labs, LUKE 1977 presents a selection of menswear that that is made to be worn on the streets, in the stands and beyond.
Connor Poole, head of sales and marketing at LUKE 1977, offering in Doncaster, after many years of amazing support from our local customers in the city.
“Opening in Doncaster Lakeside Village allows us to offer even more fantastic styles, alongside exclusive ranges, only available in LUKE 1977 stores.
“We look forward to welcoming our existing fans alongside new customers, into our store and our ever-growing LUKE 1977 family.”
Wentworth Woodhouse celebrates major European award

Members of a Chinese community group helped Wentworth Woodhouse to celebrate its win in Europe’s most prestigious cultural heritage awards.
The restoration of the Grade II* Camellia House in the gardens of the Rotherham mansion was named as the UK’s only winner in the Europa Nostra Awards 2025.
The Camellia House is home to one of the oldest surviving collections of camellias, which were brought from China 150 years ago. Members of the South Yorkshire WH Community, a voluntary group which supports Chinese people living in Rotherham, were thrilled to see their native blooms.
Presenting the award in the category of Conservation and Adaptive Reuse, Europa Nostra Board Member Graham Bell praised Wentworth Woodhouse Preservation Trust and its team for their ‘gumption’.
Sue Ryder Christmas Treecycling Leeds
National healthcare charity Sue Ryder is inviting residents to participate in their Christmas Treecycling scheme to help raise much-needed money for families in need of palliative and bereavement care.
With an optional donation to Sue Ryder, a team of friendly, reliable volunteers will collect your real Christmas tree directly from your front door, garden, or driveway and recycle them.
As part of Christmas Treecycling, residents in Leeds in LS6, LS7, LS8, LS14, LS15, LS16, LS17, LS18, LS19, LS20, LS21, LS26, LS27, LS28 postcodes can have their trees collected between 7-13 January 2026.
Your real Christmas tree will be recycled into compost or wood chippings which will be used in local parks and woodlands or to generate green energy.
To learn more about this eco-friendly fundraising initiative in Leeds - kindly sponsored by JT Atkinson, Plant Commercial Sales Plantforce Leeds and supported by The Waste Team, Bagnalls, B Houldsworth and Sons, Enterprise Leeds, NG Bailey, Farmac Building Supplies, Woodhall Hills Golf Club, Urban Forestry and Leeds Council - and to reserve a collection by midnight on 4 January 2026, visit www.sueryder.org/treeleeds
with any queries on 0113 203 3336 or email: fundraising@sueryder.org
Christmas events
There’s lots happening in Bawtry in the run-up to Chrsitmas
• Visit Bawtry Christmas Farmers Market - Sunday 14 December 10am-3pm
• Visit Bawtry Christmas Antiques Market - Sunday 21 December 10am-3pm
• Late Night Shopping Events - Thursday 11 and 18 December 5pm-8pm with free parking on Market Hill thanks to Bawtry Town Council
Lots of other events happing in the town throughout December. For more information check out the Visit Bawtry Facebook page.
Bumper Xmas Quiz Answers
FILM & TV: 1. Lady Sybil 2. The Dog in the Pond 3. Iain Stirling 4. Jennifer Love Hewitt and Freddie Prinze Jr 5. Margaret Qualley 6. Alistair Sim 7. Greg Davies 8. Only Fools and Horses 9. Beverly D’Angelo 10. Ada Thorne MUSIC: 1. Ozzy Osbourne 2. Coachella 3. Disease 4. Diana Ross 5. Bad Bunny 6. Paul David Hewson 7. 1977 8. Messy by Lola Young 9. Austria (Wasted Love by JJ) 10. Sam Fender GENERAL KNOWLEDGE: 1. The Battle of Bosworth Field 2. Ulaanbaatar 3. Flamboyance 4. 1801 5. Ag 6. 2007 7. Travis Kelce 8. Henry VII 9. Horse 10. Unicorn CURRENT AFFAIRS: 1. Angela Rayner 2. Larry Ellison 3. Jane Austen 4. Bradford 5. John Swinney 6. Dame Sarah Mullally 7. Canada 8. 20 January 2025 9. Nintendo Switch 2 10. Pope Leo XIV SPORT: 1. France and Wales 2. Nick Rockett 3. 2009 4. Zhao Xintong 5. Iga Swiatek and Jannik Sinner 6. Lewis Hamilton and Michael Schumacher (7 each) 7. Shane Lowry 8. Ben Stokes 9. Blue, yellow, black, green, and red 10. Mohammed Salah CHRISTMAS: 1. Blitzen 2. Capricorn 3. Denmark 4. Four (Jacob Marley, the ghosts of Christmas Past, Present and Future) 5. Seven swans a-swimming 6. Aldi 7. Benedict Cumberbatch 8. Poland 9. Advocaat 10. Paris




























































